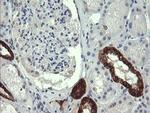
GBAS Antibody in Immunohistochemistry (Paraffin) (IHC (P))

Search
OriGene
GBAS Monoclonal Antibody (OTI1B8), TrueMAB™
{{$productOrderCtrl.translations['antibody.pdp.commerceCard.promotion.promotions']}}
{{$productOrderCtrl.translations['antibody.pdp.commerceCard.promotion.viewpromo']}}
{{$productOrderCtrl.translations['antibody.pdp.commerceCard.promotion.promocode']}}: {{promo.promoCode}} {{promo.promoTitle}} {{promo.promoDescription}}. {{$productOrderCtrl.translations['antibody.pdp.commerceCard.promotion.learnmore']}}
产品信息
TA505590
种属反应
宿主/亚型
分类
类型
克隆号
抗原
偶联物
形式
浓度
纯化类型
保存液
内含物
保存条件
运输条件
靶标信息
GBAS encodes a protein belonging to the NipSnap family, which is believed to participate in vesicular transport. This protein is primarily found in mitochondria and is involved in oxidative phosphorylation. A non-functional version of this gene is located on the long arm of chromosome 2. Multiple isoforms of this gene have been identified due to alternative splicing. NIPSNAP2 is linked to several diseases such as Phosphoserine Phosphatase Deficiency and Mast Syndrome.
仅用于科研。不用于诊断过程。未经明确授权不得转售。
篇参考文献 (0)
生物信息学
蛋白别名: 4-nitrophenylphosphatase domain and non-neuronal SNAP25-like 2; glioblastoma amplified sequence; Glioblastoma-amplified sequence; NipSnap2; Protein NipSnap homolog 2
基因别名: AV006093; GBAS; NIPSNAP2
UniProt ID: (Human) O75323
Entrez Gene ID: (Human) 2631, (Mouse) 14467, (Rat) 498174, (Dog) 479700